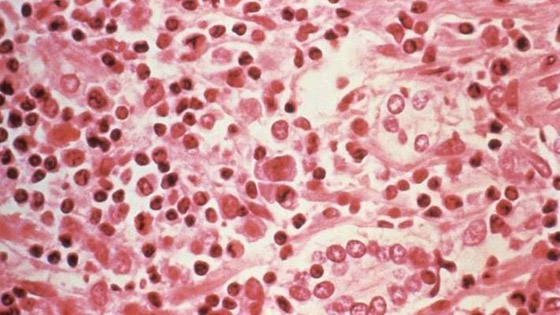

تناقلت وسائل إعلام مختلفة خبرا نشرته صحيفة صينية عن حالة وفاة لرجل في مقاطعة يونان، ولكنها هذه المرة غير مرتبطة بفيروس كورونا الجديد "كوفيد-19"، وإنما بفيروس آخر. ووفقا لصحيفة صينية، التي أوردت الخبر أول مرة، فقد توفي الرجل، الاثنين الماضي، جراء فيروس "رئوي نادر" يعرف باسم "فيروس هانتا"، وهي فصيلة من الفيروسات تنتشر بواسطة القوارض.

انتقال الفيروس
بحسب المراكز الأميركية لمكافحة الأمراض والوقاية منها، فإن حالات "فيروس هانتا" نادرة، وتنتشر عادة في المناطق الريفية حيث توفر الغابات والحقول والمزارع موطنا مناسبا لمضيفات القوارض للفيروس. كذلك فإن المناطق المحيطة بالمنزل أو العمل التي قد تعيش فيها القوارض (على سبيل المثال، المنازل والحظائر والمباني الملحقة والمظلات) هي مواقع محتملة قد يتعرض فيها الناس للفيروس. وتنجم العدوى نتيجة الاتصال الوثيق مع بول أو روث أو لعاب القوارض أو عن طريق استنشاق الهواء الملوث بالفيروس، ويمكن أن تحمله أنواع معينة من الجرذان والفئران.

وأوضحت المراكز الأميركية لمكافحة الأمراض أن كل سلالة من "فيروسات هانتا" مرتبطة بأنواع مضيفة من القوارض، وأن هذه الفيروسات تنتقل في ما يعرف بـ"الانتقال الجوي"، أي بواسطة الهواء المحيط، عندما تنتقل جزيئات الفيروس من بول الحيوان أو البراز أو اللعاب في الهواء وتصيب الفرد. وفي حالات نادرة، قد يصاب الشخص بفيروس هانتا، إذا عضه حيوان مصاب.
ويعتقد الخبراء أنه من الممكن الإصابة بالفيروس إذا لمس الشخص فمه أو أنفه بعد التعامل مع سطح ملوث ببول أو روث أو لعاب المضيف، وكذلك إذ تناول طعاما ملوثا. ويعرف المرض في الولايات المتحدة باسم "المتلازمة الرئوية لفيروس هانتا" (إتش بي أس)، لكن في أوروبا وآسيا يعرف باسم "الحمى النزفية مع المتلازمة الكلوية" (إتش إف آر أس). وكان الفيروس قد انتشر سابقا في كل من الولايات المتحدة وتشيلي والأرجنتين، حيث عرف أيضا باسم "فيروس الأنديز".

أعراض المرض
تشمل أعراض الإصابة بفيروس هانتا التهاب المفاصل الروماتويدي، والإرهاق والتعب، والحمى وأوجاع العضلات، خاصة في الفخذين والظهر والوركين، وبشكل أقل في الكتفين، وقد يشعر الشخص المصاب أيضا بالدوار والصداع والقشعريرة والقيء والإسهال وآلام المعدة.
وخلال فترة تتراوح بين 4 إلى 10 أيام ، يمكن أن يصاب الشخص بضيق في التنفس والسعال، وقد تمتلئ رئتيه بالسوائل، وتصل نسبة الوفاة بالفيروس بعد هذه المرحلة إلى 38 في المئة من الحالات. أما في حالات "الحمى النزفية مع المتلازمة الكلوية"، فتظهر أعراض الشخص بسرعة، وتشمل آلام الظهر والمعدة والصداع والقشعريرة والغثيان والحمى، قد تترافق في بعض الأحيان مع ضبابية الرؤية، وقد يصبح الوجه أحمر أو ملتهبا، ويمكن أن يتبعه انخفاض ضغط الدم، بالإضافة إلى الصدمة الحادة، والفشل الكلوي الحاد، وتبلغ نسبة الوفاة هنا بين 1 إلى 15 في المئة.

خطورته لا تقلّ عن كورونا، لكن لا داعي للهلع.. كل ما تريد معرفته عن فيروس هانتا بالتفاصيل
ففي الوقت الذي تُسابق فيه حكومات العالم الزمنَ للحدِّ من تفشي الوباء الذي سببه فيروس كورونا، ظهرت أنباء من الصين عن وفاة شخص بفيروس هانتا. فما هو فيروس هانتا؟ وهل من داعٍ للخوف منه؟ هل من الممكن أن يسبب نفس حالة الارتباك والهلع التي تسبَّب بها كورونا؟
لنبدأ أولاً بما حدث مع الرجل الصيني. صحيفة صينية نشرت تغريدةً مفادها أن رجلاً من مقاطعة يونان توفي أثناء ذهابه للعمل على متن حافلة يوم الإثنين. الحكومة الصينية سارعت إلى اختبار 32 شخصاً آخر كانوا على متن الحافلة خوفاً من انتقال عدوى فيروس هانتا أو Hanta Virus.

الخبر سرعان ما انتشر عبر مواقع التواصل الاجتماعي، ليصبح ترينداً عالمياً، ويقدم صفعةً أخرى للبشرية التي لم تنته بعدُ من جولة معركتها الأولى مع فيروس كورونا المستجد، الذي تجاوز عدد مصابيه 400 ألف حول العالم، في حين تجاوز عدد الوفيات 17 ألفاً، وذلك منذ ظهور المرض بمدينة ووهان، في ديسمبر/كانون الأول 2019.
ما هو فيروس هانتا؟
بدايةً، لا بد أن تعلم أن فيروس هانتا ليس جديداً، وهو ينتقل إلى البشر من القوارض حال استنشاق فضلاتها، أو ملامسة بولها أو لعابها. يتسبب بعدها الفيروس فيما يسمى متلازمة فيروسات هانتا الرئوية (HPS)، وهو مرض تنفسي شديد وقاتل في بعض الحالات.

ينتقل الفيروس بعد استنشاقه إلى الرئتين ليستقر هناك، حيث يبدأ هجومه على الخلايا الرئوية؛ فيبدأ في غزو الأوعية الدموية الدقيقة التي تسمى الشعيرات الدموية. ثم تنغمر الرئتان بالسوائل، وهو أمرٌ خطير تنجم عنه مشاكل الجهاز التنفسي المرتبطة بمتلازمة الرئة الناجمة عن فيروس هانتا.
كما يمكن أن ينتقل للإنسان إذا لمس الشخص فمه أو أنفه بعد التعامل مع سطح ملوث ببول أو روث أو لعاب حيوان يحمل الفيروس. وقد ينتقل المرض أيضاً عبر تناول طعام ملوث ببول أو براز حيوان مصاب، أو إذا لامست الفضلات جرحاً مفتوحاً على جسم الإنسان أو إذا تعرض لعضة من إحدى القوارض.

ما هو موطن فيروس هانتا؟
لا تعد الصين موطن هذا الفيروس القديم، إذ سبق أن ظهر في كل من أمريكا الشمالية والجنوبية وفي كوريا، وفق ما أوضح المركز الأمريكي للسيطرة على الأمراض CDC. في أمريكا الشمالية لم يتحول الفيروس إلى عدوى بين البشر، بعكس ما حصل في أمريكا الجنوبية، وهو ما يعني وجود أكثر من سلالة للفيروس.
لماذا سُمي بفيروس هانتا؟
تم اختيار تسمية Hantavirus نسبة لمنطقة نهر Hantan في كوريا الجنوبية، حيث لوحظ تفشٍّ مبكر بين الفئران، وتم عزله في عام 1976 بواسطة عالم الأوبئة والفيروسات Ho-Wang Lee.

ما هي عوارض فيروس هانتا؟
وفقاً لموقع صيني طبي، تتفاقم متلازمة هانتا الرئوية خلال مرحلتين:
الأولى تتميز بأعراض تشبه الإنفلونزا العادية مثل:
- الحمى.
- القشعريرة.
- الصداع.
- آلام العضلات.
- القيء والإسهال.
- آلام البطن.
في هذه المرحلة المبكرة، يصعب تمييز فيروس هانتا عن الإنفلونزا أو الالتهاب الرئوي أو الفيروسات الأخرى.

والثانية بعد 4 إلى 10 أيام، حين تظهر علامات وأعراض أكثر خطورةً مثل:
- رؤية ضبابية.
- السعال الذي يُنتج إفرازات لعابية.
- ضيق التنفس.
- تراكم السوائل داخل الرئتين.
- انخفاض ضغط الدم.
- تراجع كفاءة القلب.
- انخفاض ضغط الدم وحدوث صدمة.
- الفشل الكلوي الحاد.
ويموت ما بين 1 إلى 15% من المرضى بهذه الحالة.

وذكر موقع طبي أنه لا يوجد علاج لهذا الفيروس أو طعم مضاد، ولكن الاكتشاف المبكر ودخول المستشفى يحسنان من فرص الشفاء منه. وغالباً ما يحتاج المصاب إلى رعاية طبية في وحدة العناية المركزة، واستخدام جهاز التنفس والعلاج بالأكسجين. وأفضل طريقة للوقاية من فيروس هانتا هي التخلّص من القوارض أو ارتداء الكمامات حين التواجد في أماكن تواجد القوارض.
متى ظهر مرض فيروس هانتا أول مرة بين البشر؟
تم اكتشاف إصابة البشر بالمرض لأول مرة في مايو/أيار 1993، حيث شهد جنوب غرب الولايات المتحدة تفشياً لمرض رئوي غير معتاد، وتحديداً في منطقة تشترك فيها أريزونا ونيومكسيكو وكولورادو ويوتاه المعروفة باسم "الزوايا الأربع". تم نقل شاب من السكان الأصليين (أو ما يسمى الهنود الحمر) يعاني من ضيق في التنفس إلى مستشفى في ولاية نيومكسيكو، لكنه توفي هناك بسرعة.

أثناء مراجعة الحالة، اكتشف الطاقم الطبي أن خطيبة الشاب توفيت قبل أيام قليلة بعد ظهور أعراض مماثلة عليها، وهي معلومة أسهمت في اكتشاف المرض وتأكيد إمكانية انتقاله بين البشر. بدأت السلطات الصحية الأمريكية تحقيقاً في منطقة "الزوايا الأربع"، لتكتشف 5 وفيات نتيجة أمراض الجهاز التنفسي.
وعلى مدى الأسابيع التالية، ظهرت المزيد من الحالات، بينما عمل الأطباء بسرعة لمحاولة التعرف على هذا الفيروس الجديد، إلى أن تمكنوا من ربط المتلازمة الرئوية بفيروس من نوع غير معروف وقتها من فئة فيروس هانتا. ومن المعلوم طبياً أن هذا الفيروس ينتقل من القوارض -كالجرذان أو الفئران- إلى البشر، لذلك كان على السلطات الوصول إلى أماكن انتشار القوارض.

وفي الفترة بين يونيو/حزيران حتى أغسطس/آب 1993، عملت الحكومة على الإمساك بجميع القوارض التي كانت تعيش في منازل المنطقة ومحيطها. لكن الباحثين قرّروا المغامرة بصحتهم شخصياً، عبر التعامل مع هذه القوارض بلا قفازات طبية أو حتى كمامات، ليدرسوا كيفية انتقال فيروس هانتا إلى البشر. جمعت السلطات نحو ألف و700 حيوان قارض، لتبدأ في إجراء الدراسات. وفي نوفمبر/تشرين الثاني 1993، نجح العلماء في فصل الفيروس وتحديده، أي في غضون شهور فقط من ظهور أول حالة في الولايات المتحدة.

لماذا ظهر الفيروس في تلك المنطقة؟
في تلك الفترة، شهدت المنطقة الجنوبية في أمريكا جفافاً لعدة سنوات، وفي بدايات العام 1993 ساعد الثلج والأمطار الغزيرة بإعادة إحياء النبات والحيوانات في المنطقة بأعداد غير مسبوقة. كان للفئران والقوارض الوفير من الطعام، فتكاثرت بسرعة وانتشرت بدرجة 10 أضعاف العام السابق.
ومع هذا الانتشار الضخم للقوارض، زادت فرص التَّماس بين البشر والقوارض، لتنتقل الأمراض من الفئران والجرذان إلى سكان المنطقة. وحتى هذه اللحظة، لم تُثبت الدراسات الأمريكية انتقال هذا الفيروس بين البشر، رغم أن تشيلي والأرجنتين شهدتا حالات نادرة انتقل فيها أحد أنواع فيروس هانتا، والمسمى فيروس الأنديز أو Andes Virus من إنسانٍ إلى آخر، إلا أن القاعدة المثبتة تَبْقَى أنَّه ينتقل من القوارض إلى البشر.

هل ظهرت حالات أخرى بعد ذلك؟
أفضت المزيد من الدراسات اللاحقة إلى وجود أكثر من فيروس يسبب مرض HPS إلى جانب فيروس هانتا، فبعدما أصيب أحد العاملين في ولاية لويزيانا البعيدة عن المنطقة الموبوءة بالمرض، في يونيو/حزيران 1993، تبيّن أنّ السبب هو فيروس يسمى بايو أو Bayou Virus، ينتشر أيضاً بين الفئران. ثم أصيب رجل آخر في فلوريدا لم يسافر إلى المنطقة هو الآخر، ليتبين لاحقاً أن السبب فيروس يسمى Black Creek Canal Virus. ثم ظهرت إصابة في مدينة نيويورك، نتيجة فيروس سمي لاحقاً بـNew York-1، الذي انتقل بسبب نوع من الفئران البيضاء.

كيف يمكننا الوقاية منه؟
وفقاً للمركز الأمريكي للسيطرة على الأمراض، فإن أفضل وسيلة للوقاية من الإصابة بفيروس هانتا هي القضاء على الاتصال مع القوارض في المنزل أو مكان العمل أو عند التخييم مثلاً. يجب التخلص من أعشاش القوارض، وإغلاق أي شقوق وثقوب في المنازل، حيث يمكن أن تدخل الفئران، أو نصب الفخاخ، ووضع السموم أو حتى تربية قطط في المنزل.
تختلف المدة التي تظل فيها فيروسات هانت معدية في البيئة، بناءً على عوامل عدة مثل النظام الغذائي للقوارض، ودرجة الحرارة والرطوبة، وما إذا كانت تعيش في الداخل أو في الهواء الطلق. وثبت أن فيروس هانت وأشباهه تظل نشطةً لمدة تتراوح بين يومين إلى 3 أيام في درجة حرارة الغرفة العادية (20-22 درجة مئوية)، بينما تقتلها الأشعة فوق البنفسجية كضوء الشمس المباشر في غضون ساعات قليلة. ومع ذلك، يجب دائماً التعامل مع فضلات القوارض على أنها معدية، وبالتالي التخلص منها، وتجنب لمسها بصورة مباشرة.
متى أراجع الطبيب؟
يمكن أن تتفاقم علامات وأعراض متلازمة فيروس هانتا فجأة، وقد تصبح مهددة للحياة بسرعة. لذا إذا تعرّضت للقوارض أو فضلاتها، ثم ظهرت عليك علامات وأعراض الحمى والقشعريرة أو آلام العضلات أو أي صعوبات في التنفس، فراجِع الطبيب فوراً. أخيراً وباختصار، رغم أن أعراض فيروس هانتا تشبه تقريباً أعراض فيروس كورونا المستحدث، فإنه ينتقل بشكل أساسي من القوارض إلى البشر، بعكس الكورونا، فلا داعي للهلع.
